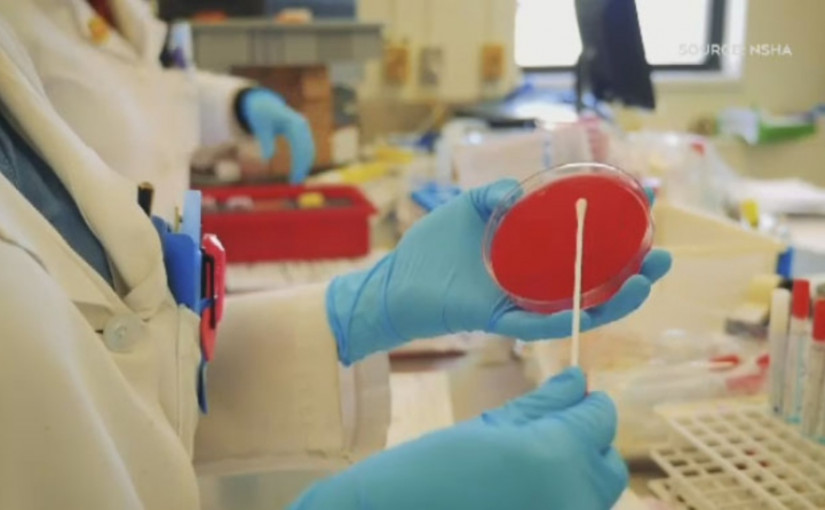

【星島溫哥華綜合報道】
卑詩衛生廳長狄德安 (Adrian Dix) 及省首席衛生官亨利醫生(Dr. Bonnie Henry)周三就省內新型冠狀病毒的最新情況發出聲明,卑詩過去一日新增21宗新冠肺炎病例,包括兩宗流行病學相關(Epi-linked)個案,令本省累計病例總數達3,149宗; 沒有增添死亡個案,死者總數維持189名,目前有207宗現存新型冠狀病毒個案。
省衛生廳周三沒有就疫情最新進展召開記者會,據最新統計顯示,卑詩省全部確診的3,149名患者中,屬於溫哥華沿岸衛生局管轄區域的有1,023人、菲沙衛生局1,659人、溫哥華島135人、內陸與北部地區分別有216和65人; 另有51名患者的主要居住地在加拿大境外地區。
目前有14名病人仍然留醫,其中5人在深切治療部(ICU), 其餘患者都在家中自我隔離及休養,至今共有2,753名對新型冠狀病毒測試呈陽性的人士完全康復,康復率為87.42%。
此外,卑詩沒有出現新的長期護理設施和社區疫情爆發,現維持兩間長期護理或支援或生活設施及1個急診設施存在疫情。卑詩省現時除有多宗社區感染事件外,還有一個現存社區疫情爆發。
狄德安與亨利表示,由於新型冠狀病毒繼續在省內社區中悄然傳播,衛生部門對最近數天新個案的增加感到憂慮。,他們稱,卑詩較早前有許多長期護理或支援式生活設施受到疫情影響,但最近大多數新增個案都發生在更廣泛的社區中。
聲明指出:「在卑詩省,隨著我們增加與他人相聚的時間,我們必須在新型冠狀病毒疫情中找到平衡。我們需要盡量減少個案數字、管理新出現的個案,並相應地調整活動。為此,我們所有人都必須盡自己本份,繼續採取多重保護、並要繼續遵循我們的安全社交互動準則。」
二人強調,沒有人希望感染病毒,也沒有人想在不經意間把病毒傳染給別人。儘管患者的症狀可能很輕微,但這是一種複雜的疾病,可以造成嚴重的後果。
他們說:「讓我們安全地享受這個夏天,並繼續竭盡所能保護我們的鄰居、朋友和親人。」
(V06)